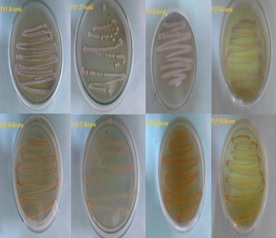
CoverFigure.jpg

Biomedical Sciences Today
A fast, peer-reviewed and multidisciplinary publication platform



Announcement from Editorial office:
We are currently accepting Commentaries, Letters, Regular Research and Review manuscripts submission for volume 4,
scheduled to be published in Fall, 2018. Please
email us your cover letter and manuscript to bmst@mdtcanada.ca (prepared following guidelines).
MDT Canada is a Canada-based company. The company aims to
provide services to solve all kinds of problems of complex systems from physics, biology to social science
using expertises in Modeling Dynamic Trends. Here are some examples!!
☛ MDT Canada provides aptamer design services.
We can "design" aptamers according to your requests utilizing the power of energetics
and entropy based techniques.Our patented, Entropic Fragment Based Approach (EFBA), is one technique used.
☛ Regarding membrane permeation of your drugs, we can test, measure and provide consultancy.
☛ We offer our expertise to set up in silico binding dynamics studies and in vitro binding
assay protocols for your laboratories. For details see www.mdtcanada.ca
Current Issue
Volume 3: July 30, 2018
EDITORIAL
Drug discovery and Clinical Treatments
REVIEW
Oral Anti-Platelet Therapy for Acute Coronary Syndrome
Molecular dynamics and related computational methods with applications to drug discovery
REGULAR ARTICLES
About the cover
EDITORIAL
Drug discovery and Clinical Treatments
Chih-Yuan Tseng
e13 |
In molecular perspective, diseases are considered to be associated with functions of specific target proteins in the body being altered to abnormal states through various mechanisms including either genetic mutations or pathogens influences. Following this concept, the goal of drug discovery is to either design or “discover” drugs that could be either small molecules, antibodies, peptides or short nucleotides to interact with target proteins to modulate their abnormal functions to treat diseases. Unfortunately, effects and efficacy of drugs can’t still be entirely predicted when patients are treated with them because complexity in proteins regulations in molecular level, pharmacokinetics and pharmacodynamics in systems level has hampered the development of optimal treatments. To accomplish the goal, one has to take all of these information into account to design appropriate drugs that can specifically interact with targets and have desire pharmacokinetic and pharmacodynamic properties, develop optimal formulations and best treatment plans. ... (PDF)
REVIEW
Oral Anti-Platelet Therapy for Acute Coronary Syndrome
Subhi J. Al’Aref, Robert M. Minutello
e14 |
In recent days, medical treatment of coronary artery disease, and more specifically acute coronary syndrome with and without revascularization, has seen significant improvement in outcomes driven by the discovery of newer P2Y12 receptor antagnosists leading to more consistent inhibition of platelet function and fewer ischemic and/or thrombotic events. This review will address a thorough analysis of this medical breakthrough. (PDF)
Molecular dynamics and related computational methods with applications to drug discovery
Jack A. Tuszynski, T. Luchko, Philip Winter, Cassandra Churchill, Kamlesh Sahu, Francesco Gentile, Sara Ibrahim Omar, N. Nayebi, G. Hu, K. Wang and J. Ruan
e15 |
The computational technique of molecular dynamics is discussed, with special attention to force fields for protein simulations and to methods for the calculation of solvation free energies. Additionally, computational methods aimed at characterizing and identifying ligand binding pockets on protein surfaces are discussed. Practical information about databases and publicly-available software of use in drug design and discovery is provided. The main objective of this paper is to give the reader a practical toolbox for applications in quantitative biology and computational drug discovery. (PDF)
REGULAR ARTICLES
Sensitivity testing, yield and stability of antimicrobial metabolites obtained from soils of Menengai crater in Kenya
Waithaka N. Paul, Mwaura B. Francis, Wagacha M. John, Gathuru M. Eliud and Githaiga M. Benson
e16 |
This study sought to determine the effectiveness of antimicrobial metabolites extracted using ethyl acetate. The antimicrobial metabolites were obtained from previously isolated actinomycetes coded as PAN 30, PAN 37, PAN 41 and PAN 154. The study also determined the yield of the extracts from the actinomycetes in addition to testing the stability of the antimicrobial metabolites to degradation by enzymes, temperature and pH. To obtain the antimicrobial metabolites from the actinomycetes, fermentation was carried out for a month using an orbital shaker. Extraction of the metabolites was carried out using ethyl acetate. The metabolites were concentrated using a vacuum evaporator. The metabolites were separately dried in pre-weighed containers using a hot air oven. To determine the weight of the antimicrobial metabolites, the concentrated antimicrobials were placed in pre-weighed containers followed by evaporation of the solvent to dryness in a hot air oven. The containers having the antimicrobial metabolites were reweighed and the weight of the antimicrobials determined by subtracting the weight of the empty container from that of the container plus the metabolites. The stability of the antimicrobial metabolites was determined by exposing the metabolites to enzymes, varying levels of temperatures and pH. The antimicrobial metabolites yield of PAN 30 was 253.6mg, PAN 37 (231.4mg), PAN 41 (258.0mg) and PAN 154 (259.0mg). There was no significant difference in the weights of the antimicrobial metabolites among the four actinomycetes. The zones of inhibition presented by Staphylococcus aureus, Bacillus subtilis, Escherichia faecalis, Escherichia coli, Klebsiella pneumoniae, Salmonella typhi, Xanthomonas campestris, Erwinia carotovora, Candida albicans, Aspergillus niger, Fusarium oxysporum and Ustilago maydis were significantly different (F=6.6046 P=0.001338). The zones of inhibition produced by the pathogens after incubating the antimicrobial metabolites to enzymes trypsin, lysozyme, pepsin and lipase in addition to temperatures of 60oC, 70oC and 80oC were not statistically different. However, there were significant differences when the antimicrobial metabolites were tested for stability against pH in bacterial (F = 319.0101 P=<0.05) and fungal (F=55.58353, P<0.05) pathogens. The antimicrobial metabolites obtained from PAN 41 and PAN 154 were not stable in trypsin, lysozyme, pepsin and lipase. All the antimicrobial metabolites remained stable at 60oC, 70oC and 80oC. In addition, the antimicrobial metabolites remained effective in pH 2, 4, 5 and 7 but were not effective in pH of 9 and 11. There is need to further purify the metabolites and determine their structure. (PDF)
Cyclobenzaprine drug assay and Cyclobenzaprine-excipient interaction study by chromatography, thermal and spectral analysis
Rajasekhar Tulasi Baru, Prasanth Bitla
e17 |
The present study was carried out to investigate the compatibility of Cyclobenzaprine hydrochloride, a muscle relaxant and antidepressant with different pharmaceutical excipients. The study involved storing drug-excipient blends (200 mg) with 20% added moisture in closed glass vials at 100°c for 24 hours. A LC method was developed and validated for determination of cyclobenzaprine. The mobile phase consists of potassium dihydrogen phosphate buffer (20 mM, pH 3.0): methanol with flow rate 1.2 mL/min and UV detection at 280 nm. A good linearity was obtained with concentration ranging from 5-50 µg/mL. The HPLC study showed, drug interacts with some commonly used pharmaceutical excipients. The results were fairly good in agreement with the cyclobenzaprine hydrochloride-excipient interaction analysis, obtained from DSC, FT-IR, UV-DRS. The HPLC method was validated as per ICH guidelines and applied for quality control of bulk and formulation of cyclobenzaprine hydrochloride. (PDF)
ISSN 2369-2103